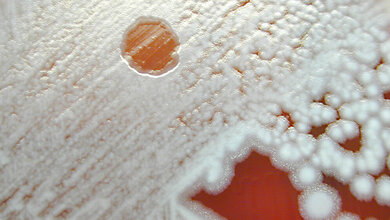
Phagen

UV-Licht: Gelingt die komplette MRSA-Sanierung?
Endlich multiresistente Erreger wie MRSA bekämpfen ohne weitere Resistenzen zu riskieren? Davon träumen Mediziner schon lange. Denn sie sind eine große Herausforderung im medizinischen Alltag, da sie oft nicht (mehr) mit Antibiotika behandelt werden können. Laut Robert Koch-Institut kommt es in Deutschland jährlich zu 400.000 bis 600.000 Infektionen mit Krankenhauskeimen – etwa 10.000 bis 20.000 Menschen sterben daran. Neue Möglichkeiten der Bekämpfung könnten Leuchtdioden (LEDs) aus dem Ferdinand-Braun-Institut, Leibniz-Institut für Höchstfrequenztechnik (FBH), die im fernen ultravioletten (UV) Spektralbereich abstrahlen, eröffnen. Der Fern-UVC-Wellenlängenbereich unter 235 Nanometern (nm) sei für medizinische Anwendungen hochinteressant. Aufgrund der hohen Absorption bei diesen Wellenlängen dringe das Licht nicht in die lebenden Schichten der Haut ein – und richte daher weniger Schaden an als ein Sonnenbrand. Die Fern-UVC-LEDs könnte somit das schaffen, was Antibiotika nicht immer gelingt: schädliche Mikroorganismen und insbesondere multiresistente Erreger (MRE) abzutöten (Eradizierung), ohne dass sich Resistenzen entwickeln.
Haut wird nicht geschädigt
Die neu entwickelten Fern-UVC-LEDs aus dem Ferdinand-Braun-Institut, die das Konzept der Mikro-LEDs nutzen, schaffen die Voraussetzungen für kompakte, fasergekoppelte medizinische Strahler, um Krankheitserreger auch in Körperöffnungen unschädlich machen zu können. Dr. Sven Einfeldt, Lableiter am FBH, der mit seinem Team über langjährige Erfahrung bei der Entwicklung von UVC-LEDs für medizinische Anwendungen verfügt, erklärt: „Bei diesen sehr kurzwelligen LEDs konnten wir internationale Rekordwerte bei Effizienz und Leistung demonstrieren – ein echter Durchbruch. Zusammen mit Partnern wollen wir nun mit einem Prototyp den Schritt vom Labor in die Anwendung gehen.“ Das Berliner Institut hat bereits erfolgreich 233 nm UVC-LEDs entwickelt und damit Flächenstrahler aufgebaut, mit denen menschliche Haut bestrahlt wurde. Das Wirkprinzip und dass die Haut nicht nachhaltig geschädigt wird, konnten umfangreiche Untersuchungen im Rahmen zweier BMFTR- geförderter Projekte an der Charité – Universitätsmedizin Berlin und Universitätsmedizin Greifswald belegen.
Einsatz im Nasen-Rachen-Raum?
Bislang erreichen diese Strahler allerdings lediglich betroffene Stellen auf der Außenhaut. Daher ging die Vision der Mediziner schon bei den damaligen Tests weiter. „Ideal wären kleine LED-Strahler mit etwa einem Milliwatt Leistung, die wir direkt in die Nase oder den Rachenraum einführen können“, so die Überlegungen von Prof. Dr. Martina Meinke, Leiterin des Zentrums für Hautphysiologie an der Klinik für Dermatologie, Venerologie und Allergologie der Charité. „Damit könnten wir MRE in ihren Rückzugsorten unschädlich machen, die bisher schwer zu erreichen sind. Nach desinfizierenden Ganzkörperwaschungen mit speziellen Waschlotionen und Mundspülungen könnte beispielsweise eine komplette MRSA-Sanierung erreicht werden.“ Inzwischen ist ein solches Nasen-Rachen-Endoskop, das die Keime in klinisch relevanten Zeiträumen reduziert, keine ferne Vision mehr. Das Ferdinand-Braun-Institut hat seine UVC-LEDs so weiterentwickelt, dass sie die geforderten Ausgangsleistungen liefern. Eingebaut in ein Endoskop ließen sich die erforderlichen Bestrahlungszeiten von etwa fünf Minuten ohne größere Wärmeentwicklung erreichen.
Anwendungen in der Antiseptik möglich
Fern-UVC-LEDs sind wegen des verwendeten Materialsystems Aluminium-Galliumnitrid (AlGaN) technologisch anspruchsvoll – lieferten jedoch bislang nicht die kommerziell erforderlichen Leistungen. Maßgeblich getrieben durch Arbeiten von Dr. Jens Raß ist es nun am FBH erstmalig gelungen, die wichtige Schwelle von 1 Milliwatt Leistung mit Fern-UVC-Licht im Dauerbetrieb (CW) aus einer Glasfaser zu überschreiten – ein internationaler Rekordwert, der erst kürzlich auf einer Konferenz vorgestellt wurde. Dies eröffne Anwendungen in der Antiseptik und in der Sensorik. Gelungen ist dies durch 235 nm UV-Mikro-LEDs, die in einer dichten Matrix angeordnet sind. Dadurch lässt sich eine fünfmal höhere Lichtmenge im Vergleich zu konventionellen Fern-UVC-LEDs in die Glasfaser einkoppeln. Die Mikro-LEDs selbst, von denen bis zu 125.000 auf einem einen Quadratmillimeter großen Chip angeordnet sind, sind mit Durchmessern von jeweils nur rund 1,5 Mikrometern extrem kompakt. Damit lässt sich nicht nur mehr Licht aus dem einzelnen Chip auskoppeln, es ist zugleich stärker gerichtet – und kann damit sehr präzise eingesetzt werden. Durch den kompakten Aufbau und die hohe Leistung eignen sich die fasergekoppelten Lichtquellen ideal für die Eradizierung multiresistenter Keime und zur Desinfektion in Körperöffnungen. Die Vision eines Strahlers zur Desinfektion im Nasen-Rachenraum rückt damit in greifbare Nähe.
Quelle: Ferdinand-Braun-Institut gGmbH Leibniz-Institut für Höchstfrequenztechnik
Artikel teilen